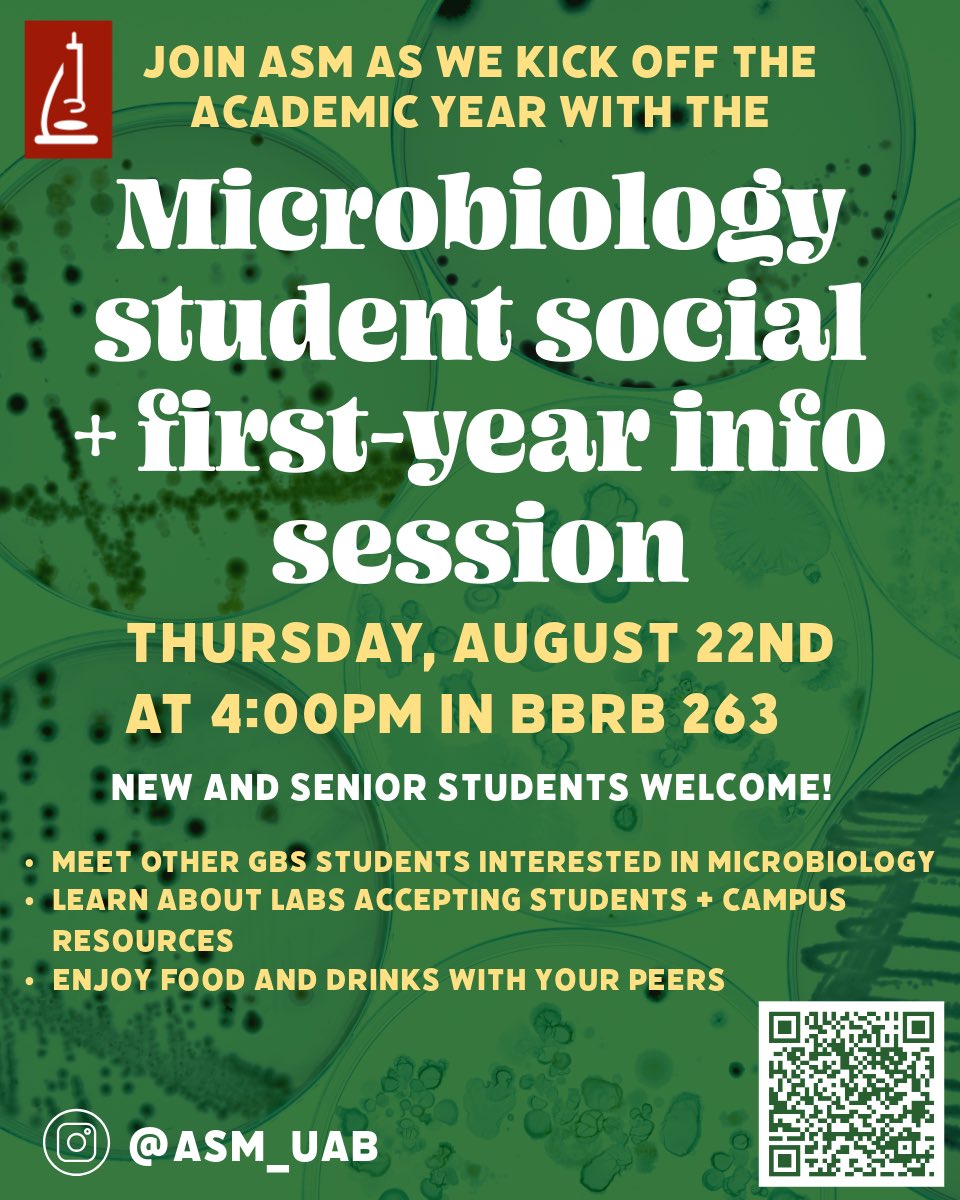
ASM @ UAB 🧫🔬🧪 tweet media

ASM @ UAB 🧫🔬🧪
24 posts


ASM @ UAB 🧫🔬🧪
@asm_uab
American Society for Microbiology (ASM) chapter at The University of Alabama at Birmingham (UAB) *student run account*
Birmingham, AL Katılım Ekim 2023
12 Takip Edilen11 Takipçiler
ASM @ UAB 🧫🔬🧪 retweetledi

Get to know @ASMicrobiology at UAB! 🌟 Read more to learn about its UAB Microbiology chapter and the value it brings to @UABHeersink. buff.ly/47MihZ5

English
ASM @ UAB 🧫🔬🧪 retweetledi

What a great ending to the year! Friendship bracelets and voting for the new ASM exec board 🎉🫶 Keep an eye on this page and our Instagram for next year’s events! #asm




English


Thanks to all who attended our Women in STEM career panel this afternoon! And thank you to our excellent panelists for all their advice 👏👩🔬🧫🦠 #womeninSTEM #WomensHistoryMonth


English

ASM is continuing our celebration of #WomensHistoryMonth with a career panel featuring a few of our own @UABMicrobiology department members! Join us on Wednesday March 20th at 12pm for FREE LUNCH and career advice 🧫🦠👩🔬#womeninSTEM

English
ASM @ UAB 🧫🔬🧪 retweetledi

Women researchers played a key role in the development of antimicrobials during the mid-20th century. This article works to highlight their work, as their contributions often went unacknowledged. asm.social/1Lf

English
ASM @ UAB 🧫🔬🧪 retweetledi

It's #InternationalWomensDay, the perfect day to share with you our 10 Inspirational Women in Microbiology Infographic!
Produced by Maja Rischer (@m_rischer), and members of the #OnThisDay team. #InspireInclusion #IWD2024

English

Join us THIS THURSDAY at 4 pm in BBRB 263 for a viewing of Hidden Figures! #WomensHistoryMonth2024 #womeninSTEM 🚀🎥

English

Thanks to all who made some cool art while learning about sexual health resources on campus for our Get Screened! joint event with GRADient! 💖🧫🦠🌈
Shoutout to @kpmakoto for the great drawing for our cards 👏


Birmingham, AL 🇺🇸 English